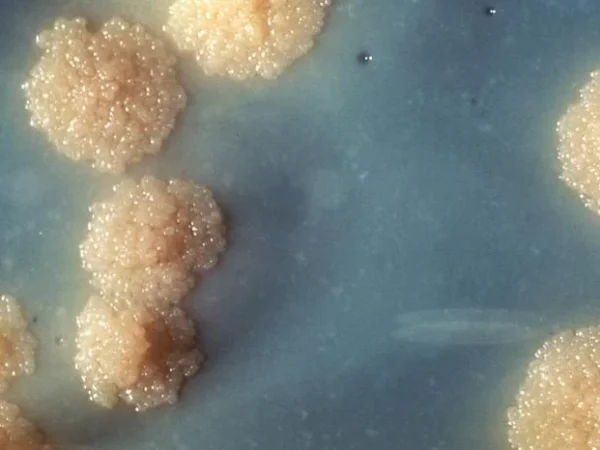

Lantik Lima Pejabat Eselon III, Kajati Jatim Dorong Respons Cepat terhadap Berbagai Persoalan Hukum Daerah
SURABAYA, Senin 23 Februari 2026 – Kepala Kejaksaan Tinggi Jawa Timur Agus Sahat ST, S.H., M.H., memimpin upacara pelantikan dan pengambilan sumpah jabatan lima pejabat eselon III di lingkungan Kejaksaan Tinggi Jawa